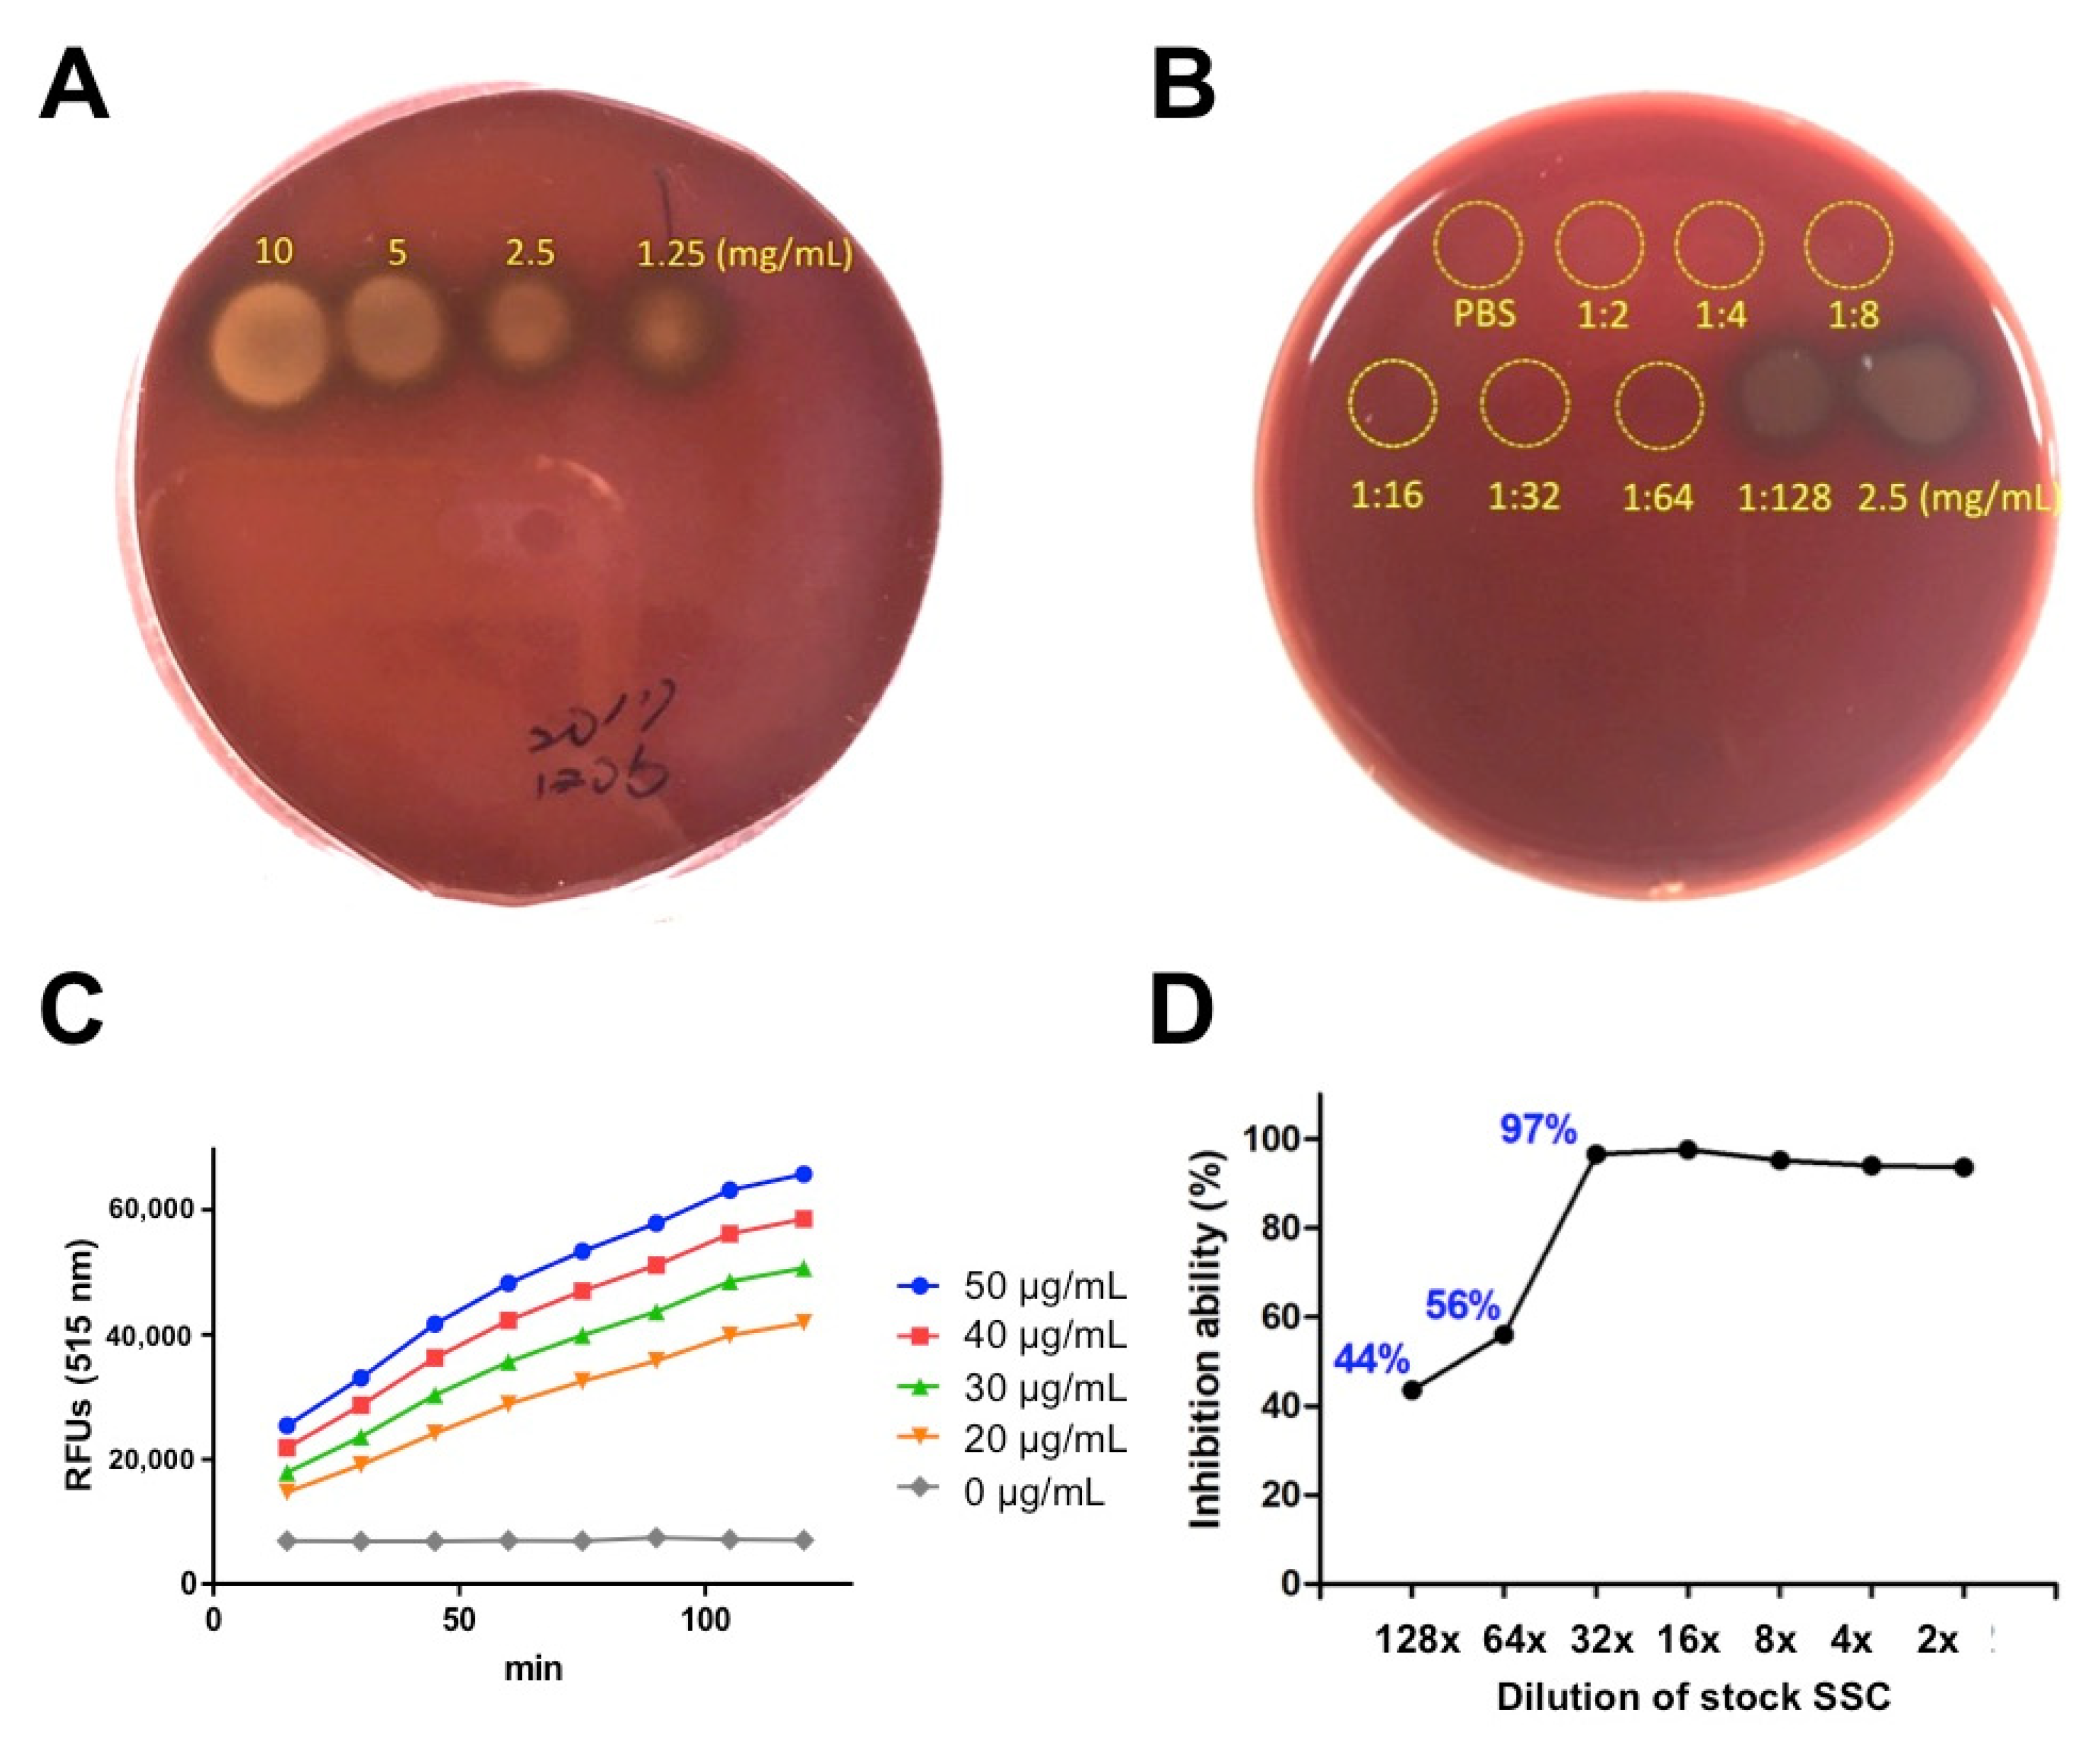
Toxins 13 00059 g002 Toxins 13 00059 g002

Effects of Sodium Silicate Complex against Hemorrhagic Activities Induced by Protobothrops mucrosquamatus Venom
Abstract
1. Introduction
2. Results
2.1. In Vitro Evaluation of SSC against Hemolytic and Proteolytic Activities Induced by P. mucrosquamatus Venom
2.2. The Hemorrhagic and Proteolytic Features of P. mucrosquamatus Venom Was Blocked by SCC Pre-Mixture
2.3. In Vivo Evaluation of Post-Treatment SSC against Intradermal Hemorrhage Induced by P. mucrosquamatus Venom
2.4. In Vivo Evaluation of Lethality Neutralization Effect of SSC against P. mucrosquamatus Venom
3. Discussion
4. Conclusions
5. Materials and Methods
5.1. Snake Venom and Chemical Materials
5.2. Blood Agar Assay
5.3. Fluorescence-Labeled Gelatin Substrate Assay
5.4. Hemorrhagic Mouse Model
5.5. Quantification of Intradermal Hemorrhage
5.6. Envenomation and Animal Survival Assays
5.7. Statistical Analysis
Author Contributions
Funding
Institutional Review Board Statement
Informed Consent Statement
Data Availability Statement
Acknowledgments
Conflicts of Interest
References
- Kasturiratne, A.; Wickremasinghe, A.R.; de Silva, N.; Gunawardena, N.K.; Pathmeswaran, A.; Premaratna, R.; Savioli, L.; Lalloo, D.G.; de Silva, H.J. The global burden of snakebite: A literature analysis and modelling based on regional estimates of envenoming and deaths. PLoS Med. 2008, 5, e218. [Google Scholar] [CrossRef] [PubMed]
- Gutierrez, J.M.; Calvete, J.J.; Habib, A.G.; Harrison, R.A.; Williams, D.J.; Warrell, D.A. Snakebite envenoming. Nat. Rev. Dis. Primers 2017, 3, 17063. [Google Scholar] [CrossRef] [PubMed]
- Evans, J.; Ownby, C.L. Neutralization of edema, hemorrhage and myonecrosis induced by North American crotalid venoms in simulated first-aid treatments. Toxicon 1999, 37, 633–650. [Google Scholar] [CrossRef]
- Rucavado, A.; Escalante, T.; Franceschi, A.; Chaves, F.; Leon, G.; Cury, Y.; Ovadia, M.; Gutierrez, J.M. Inhibition of local hemorrhage and dermonecrosis induced by Bothrops asper snake venom: Effectiveness of early in situ administration of the peptidomimetic metalloproteinase inhibitor batimastat and the chelating agent CaNa2EDTA. Am. J. Trop. Med. Hyg. 2000, 63, 313–319. [Google Scholar] [CrossRef] [PubMed]
- Russell, F.E.; Ruzic, N.; Gonzalez, H. Effectiveness of antivenin (Crotalidae) polyvalent following injection of Crotalus venom. Toxicon 1973, 11, 461–464. [Google Scholar] [CrossRef]
- Anai, K.; Sugiki, M.; Yoshida, E.; Maruyama, M. Neutralization of a snake venom hemorrhagic metalloproteinase prevents coagulopathy after subcutaneous injection of Bothrops jararaca venom in rats. Toxicon 2002, 40, 63–68. [Google Scholar] [CrossRef]
- Bjarnason, J.B.; Fox, J.W. Hemorrhagic metalloproteinases from snake venoms. Pharmacol. Ther. 1994, 62, 325–372. [Google Scholar] [CrossRef]
- Gutierrez, J.M.; Rucavado, A. Snake venom metalloproteinases: Their role in the pathogenesis of local tissue damage. Biochimie 2000, 82, 841–850. [Google Scholar] [CrossRef]
- Chang, K.C.; Huang, Y.K.; Chen, Y.W.; Chen, M.H.; Tu, A.T.; Chen, Y.C. Venom Ophthalmia and Ocular Complications Caused by Snake Venom. Toxins 2020, 12. [Google Scholar] [CrossRef]
- Perez, J.C.; Sanchez, E.E. Natural protease inhibitors to hemorrhagins in snake venoms and their potential use in medicine. Toxicon 1999, 37, 703–728. [Google Scholar] [CrossRef]
- Albulescu, L.O.; Hale, M.S.; Ainsworth, S.; Alsolaiss, J.; Crittenden, E.; Calvete, J.J.; Evans, C.; Wilkinson, M.C.; Harrison, R.A.; Kool, J.; et al. Preclinical validation of a repurposed metal chelator as an early-intervention therapeutic for hemotoxic snakebite. Sci. Transl. Med. 2020, 12, eaay8314. [Google Scholar] [CrossRef]
- Bjarnason, J.B.; Tu, A.T. Hemorrhagic toxins from Western diamondback rattlesnake (Crotalus atrox) venom: Isolation and characterization of five toxins and the role of zinc in hemorrhagic toxin e. Biochemistry 1978, 17, 3395–3404. [Google Scholar] [CrossRef]
- Ownby, C.L.; Tu, A.T.; Kainer, R.A. Effect of diethylenetriaminepentaacetic acid and procaine on hemorrhage induced by rattlesnake venom. J. Clin. Pharmacol. 1975, 15, 419–426. [Google Scholar] [CrossRef] [PubMed]
- Friederich, C.; Tu, A.T. Role of metals in snake venoms for hemorrhagic, esterase and proteolytic activities. Biochem. Pharmacol. 1971, 20, 1549–1556. [Google Scholar] [CrossRef]
- Ownby, C.L. The Merck Manual of Diagnosis and Therapy, 13th ed.; Talbott, R.B.J.H., Ed.; Merck: Kenilworth, NJ, USA, 1972. [Google Scholar]
- Cisneros, I. Method for Treating Venomous Bites and Stings. U.S. Patent Application No. 13/762,118, 27 March 2014. [Google Scholar]
- Elmore, A.R. Cosmetic Ingredient Review Expert Panel. Final report on the safety assessment of potassium silicate, sodium metasilicate, and sodium silicate. Int. J. Toxicol. 2005, 24 (Suppl. S1), 103–117. [Google Scholar] [CrossRef] [PubMed]
- Capalbo, E.L.; Townsend, D.L.; White, L.M.; Chestnut, T.; Duesler, S.; Cisneros, I.; Richardson, C.R.; Vattem, D.A. Cancer Chemotherapeutic Effects of Modified Sodium Silicate (Alkahydroxy/Alka V6TM); Texas State University, Orizon Research Institute: San Marcos, TX, USA, 2010. [Google Scholar]
- Richardson, R.C.; Vattem, D.A. Test the Cancer Chemotherapeutic and Anti-Retroviral Effects of Alka-v6 in Cell Cultures and Other In Vitro Systems; Texas State University, Orizon Research Institute: San Marcos, TX, USA, 2009. [Google Scholar]
- Guo, P.; Liu, Q.; Wen, T.; Xiao, R.; Fang, M.; Zhong, G.; Truong, N.Q.; Zhu, F.; Jadin, R.C.; Li, C. Multilocus phylogeny of the Asian Lance-headed pitvipers (Squamata, Viperidae, Protobothrops). Zootaxa 2016, 4093, 382–390. [Google Scholar] [CrossRef]
- Terada, K. The distribution, population density and controls of Protobothrops mucrosquamatus, Protobothrops elegans, Elaphe taeniura friesei, 3 snake species established on Okinawa Island. Bull. Herpetol. Soc. Jpn. 2011, 2, 161–168. [Google Scholar]
- Vasaruchapong, T.; Laoungbua, P.; Tangrattanapibul, K.; Tawan, T.; Chanhome, L. Protobothrops mucrosquamatus (Cantor, 1839), a highly venomous species added to the snake fauna of Thailand (Squamata: Viperidae). Trop. Nat. History 2017, 17, 111–115. [Google Scholar]
- Sawai, Y.; Tseng, S.C. Snakebites on Taiwan. Snake 1969, 1, 9–18. [Google Scholar]
- Chen, Y.W.; Chen, M.H.; Chen, Y.C.; Hung, D.Z.; Chen, C.K.; Yen, D.H.; Huang, C.I.; Lee, C.H.; Wang, L.M.; Yang, C.C. Differences in clinical profiles of patients with Protobothrops mucrosquamatus and Viridovipera stejnegeri envenoming in Taiwan. Am. J. Trop. Med. Hyg. 2009, 80, 28–32. [Google Scholar] [CrossRef]
- Liao, W.B.; Lee, C.W.; Tsai, Y.S.; Liu, B.M.; Chung, K.J. Influential factors affecting prognosis of snakebite patients management: Kaohsiung Chang Gung Memorial Hospital experience. Chang. Gung Med. J. 2000, 23, 577–583. [Google Scholar] [PubMed]
- Bon, C.; Burnouf, T.; Gutiérrez, J.M.; Padilla, A.; Ratanabanangkoon, A.; Warrell, D.A. WHO Guidelines for the Production, Control and Regulation of Snake Antivenom Immunoglobulins; WHO Technical Report Series; WHO: Geneva, Switzerland, 2010. [Google Scholar]
- Gutierrez, J.M. Improving antivenom availability and accessibility: Science, technology, and beyond. Toxicon 2012, 60, 676–687. [Google Scholar] [CrossRef] [PubMed]
- Yeh, Y.T.; Chen, M.H.; Chang, J.C.; Fan, J.S.; Yen, D.H.; Chen, Y.C. Protobothrops mucrosquamatus Bites to the Head: Clinical Spectrum from Case Series. Am. J. Trop Med. Hyg 2018, 99, 753–755. [Google Scholar] [CrossRef]
- Chiu, H.F.; Chen, I.J.; Teng, C.M. Edema formation and degranulation of mast cells by a basic phospholipase A2 purified from Trimeresurus mucrosquamatus snake venom. Toxicon 1989, 27, 115–125. [Google Scholar] [CrossRef]
- Wang, J.P.; Teng, C.M. Roles of PMN leucocytes, platelets and some mediators in rat hind-paw oedema induced by two phospholipase A2 enzymes from Trimeresurus mucrosquamatus venom. J. Pharm. Pharmacol. 1992, 44, 300–305. [Google Scholar] [CrossRef]
- Teng, C.M.; Hsu, M.F.; Wang, J.P. Comparison of kinin-forming and amidolytic activities of four trimucases, oedema-producing and kinin-releasing enzymes, from Trimeresurus mucrosquamatus venom. J. Pharm. Pharmacol. 1992, 44, 306–310. [Google Scholar] [CrossRef]
- Villalta, M.; Pla, D.; Yang, S.L.; Sanz, L.; Segura, A.; Vargas, M.; Chen, P.Y.; Herrera, M.; Estrada, R.; Cheng, Y.F.; et al. Snake venomics and antivenomics of Protobothrops mucrosquamatus and Viridovipera stejnegeri from Taiwan: Keys to understand the variable immune response in horses. J. Proteom. 2012, 75, 5628–5645. [Google Scholar] [CrossRef]
- Mao, Y.C.; Liu, P.Y.; Chiang, L.C.; Lee, C.H.; Lai, C.S.; Lai, K.L.; Lin, W.L.; Su, H.Y.; Ho, C.H.; Doan, U.V.; et al. Clinical manifestations and treatments of Protobothrops mucrosquamatus bite and associated factors for wound necrosis and subsequent debridement and finger or toe amputation surgery. Clin. Toxicol. 2021, 59, 28–37. [Google Scholar] [CrossRef]
- Ye, Q.; Chen, W.; Huang, H.; Tang, Y.; Wang, W.; Meng, F.; Wang, H.; Zheng, Y. Iron and zinc ions, potent weapons against multidrug-resistant bacteria. Appl. Microbiol. Biotechnol. 2020, 104, 5213–5227. [Google Scholar] [CrossRef]
- Newbrun, E.; Hoover, C.I.; Ryder, M.I. Bactericidal action of bicarbonate ion on selected periodontal pathogenic microorganisms. J. Periodontol. 1984, 55, 658–667. [Google Scholar] [CrossRef]
- Vattem, D.A.; Maitin, V.; Richardson, C.R. Evaluation of antibacterial and toxicological effects of a novel sodium silicate complex. Res. J. Microbiol. 2012, 7, 191–198. [Google Scholar] [CrossRef]
- Wei, J.F.; Li, T.; Wei, X.L.; Sun, Q.Y.; Yang, F.M.; Chen, Q.Y.; Wang, W.Y.; Xiong, Y.L.; He, S.H. Purification, characterization and cytokine release function of a novel Arg-49 phospholipase A(2) from the venom of Protobothrops mucrosquamatus. Biochimie 2006, 88, 1331–1342. [Google Scholar] [CrossRef] [PubMed]
- Wei, J.F.; Wei, X.L.; Chen, Q.Y.; Huang, T.; Qiao, L.Y.; Wang, W.Y.; Xiong, Y.L.; He, S.H. N49 phospholipase A2, a unique subgroup of snake venom group II phospholipase A2. Biochim. Biophys. Acta 2006, 1760, 462–471. [Google Scholar] [CrossRef] [PubMed]
- Chen, L.N.; Liu, C.S.; Chang, C.C. Isolation and characterization of a toxic phospholipase A2 from the venom of the Taiwan habu (Trimeresurus mucrosquamatus). Biotechnol. Appl. Biochem. 1994, 19, 61–73. [Google Scholar]
- Tsai, I.H.; Lu, P.J.; Wang, Y.M.; Ho, C.L.; Liaw, L.L. Molecular cloning and characterization of a neurotoxic phospholipase A2 from the venom of Taiwan habu (Trimeresurus mucrosquamatus). Biochem. J. 1995, 311 Pt 3, 895–900. [Google Scholar] [CrossRef]
- Ho, C.L.; Teng, C.M.; Lee, C.Y. Presynaptic and musculotropic effects of a basic phospholipase A2 from the Formosan habu (Trimeresurus mucrosquamatus) venom. Toxicon 1984, 22, 813–816. [Google Scholar] [CrossRef]
- Wang, J.P.; Peng, H.C.; Teng, C.M. Rat hind-paw swelling effect of an edema-producing protein isolated from Trimeresurus mucrosquamatus snake venom. Naunyn Schmiedebergs Arch. Pharmacol. 1991, 343, 399–404. [Google Scholar] [CrossRef]
- Ullah, A.; Souza, T.A.; Zanphorlin, L.M.; Mariutti, R.B.; Santana, V.S.; Murakami, M.T.; Arni, R.K. Crystal structure of Jararacussin-I: The highly negatively charged catalytic interface contributes to macromolecular selectivity in snake venom thrombin-like enzymes. Protein Sci. 2013, 22, 128–132. [Google Scholar] [CrossRef]
- Mao, Y.C.; Hung, D.Z. Management of Snake Envenomation in Taiwan; Gopalakrishnakone, P., Faiz, A., Fernando, R., Gnanathasan, C.A., Habib, A.G., Yang, C.-C., Eds.; Springer: Singapore, 2015; pp. 23–52. [Google Scholar]
- Chen, Y.C.; Chen, M.H.; Wang, L.M.; Wu, J.J.; Huang, C.I.; Lee, C.H.; Yen, D.H.; Yang, C.C. Antivenom therapy for crotaline snakebites: Has the poison control center provided effective guidelines? J. Formos. Med. Assoc. 2007, 106, 1057–1062. [Google Scholar] [CrossRef][Green Version]
- Jenkins, T.P.; Sanchez, A.; Segura, A.; Vargas, M.; Herrera, M.; Stewart, T.K.; Leon, G.; Gutierrez, J.M. An improved technique for the assessment of venom-induced haemorrhage in a murine model. Toxicon 2017, 139, 87–93. [Google Scholar] [CrossRef]

Publisher’s Note: MDPI stays neutral with regard to jurisdictional claims in published maps and institutional affiliations. |
© 2021 by the authors. Licensee MDPI, Basel, Switzerland. This article is an open access article distributed under the terms and conditions of the Creative Commons Attribution (CC BY) license (http://creativecommons.org/licenses/by/4.0/).
Share and Cite
Chen, Y.-C.; Wang, T.-Y.; Huang, Y.-K.; Chang, K.-C.; Chen, M.-H.; Liu, C.-C.; Liu, K.-L.; Yang, Y.-H.; Yen, D.H.-T.; Fan, J.-S. Effects of Sodium Silicate Complex against Hemorrhagic Activities Induced by Protobothrops mucrosquamatus Venom. Toxins 2021, 13, 59. https://doi.org/10.3390/toxins13010059
Chen Y-C, Wang T-Y, Huang Y-K, Chang K-C, Chen M-H, Liu C-C, Liu K-L, Yang Y-H, Yen DH-T, Fan J-S. Effects of Sodium Silicate Complex against Hemorrhagic Activities Induced by Protobothrops mucrosquamatus Venom. Toxins. 2021; 13(1):59. https://doi.org/10.3390/toxins13010059
Chicago/Turabian StyleChen, Yen-Chia, Tse-Yao Wang, Yu-Kai Huang, Kun-Che Chang, Min-Hui Chen, Chien-Chun Liu, Kuei-Lin Liu, Ya-Han Yang, David Hung-Tsang Yen, and Ju-Sing Fan. 2021. "Effects of Sodium Silicate Complex against Hemorrhagic Activities Induced by Protobothrops mucrosquamatus Venom" Toxins 13, no. 1: 59. https://doi.org/10.3390/toxins13010059
APA StyleChen, Y.-C., Wang, T.-Y., Huang, Y.-K., Chang, K.-C., Chen, M.-H., Liu, C.-C., Liu, K.-L., Yang, Y.-H., Yen, D. H.-T., & Fan, J.-S. (2021). Effects of Sodium Silicate Complex against Hemorrhagic Activities Induced by Protobothrops mucrosquamatus Venom. Toxins, 13(1), 59. https://doi.org/10.3390/toxins13010059

